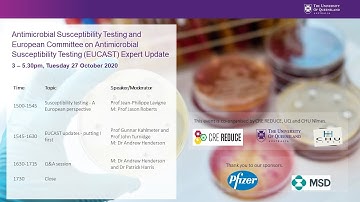
Antimicrobial Susceptibility Testing and EUCAST Expert Update - Prof Jean Philippe Lavigne

⬇ DOWNLOAD NOW
Jika muncul iklan pop-up, tutup lalu klik tombol kembali
Download lagu EUCAST new definitions of S, I and R and the Area of Technical Uncertainty ATU secara gratis hanya untuk keperluan promosi. Dukung artis favorit kamu dengan membeli musik original di iTunes atau platform resmi lainnya.
 EUCAST new definitions of S, I and R and the Area of Technical Uncertainty (ATU)
EUCAST new definitions of S, I and R and the Area of Technical Uncertainty (ATU) EUCAST online seminar on the "EUCAST new definitions of S, I and R"
EUCAST online seminar on the "EUCAST new definitions of S, I and R" UK NEQAS Microbiology Online Training - EUCAST New Definitions of S,I, R Categories use of ATU
UK NEQAS Microbiology Online Training - EUCAST New Definitions of S,I, R Categories use of ATU 20190204 EUCAST eng
20190204 EUCAST eng AMR MOOC 3- Laboratory setup, DIY techniques and Antimicrobial susceptibility testing
AMR MOOC 3- Laboratory setup, DIY techniques and Antimicrobial susceptibility testing ICC 2024 | The quirks of the EUCAST susceptibility testing system presented by Gunnar Kahlmeter
ICC 2024 | The quirks of the EUCAST susceptibility testing system presented by Gunnar Kahlmeter October, 2024, AMR CoP ECHO Session: EUCAST system and EUCAST clinical breakpoints
October, 2024, AMR CoP ECHO Session: EUCAST system and EUCAST clinical breakpoints Antimicrobial Susceptibility Testing and EUCAST Expert Update - Prof Jean Philippe Lavigne
Antimicrobial Susceptibility Testing and EUCAST Expert Update - Prof Jean Philippe Lavigne